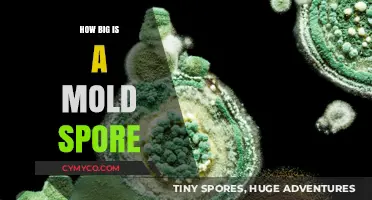
Unveiling the Microscopic World: The Astonishing Size of Mold Spores

The question Can you bonemeal spore blossoms? pertains to the popular sandbox video game Minecraft. In Minecraft, bonemeal is a fertilizer item that can be used to grow plants and flowers more quickly. Spore blossoms, on the other hand, are a type of flower that can be found in the game's Nether dimension. They are known for their unique appearance and ability to spread spores when broken. The query likely arises from a player's curiosity about whether bonemeal can be used to accelerate the growth of spore blossoms, which would be a useful tactic for cultivating these flowers more efficiently.
Explore related products
What You'll Learn
- Crafting Recipe: Bone meal and spore blossoms combine to create a powerful fertilizer in Minecraft
- Ingredient Sources: Bone meal is obtained from bones, while spore blossoms are found in the Nether
- Usage Benefits: The mixture accelerates plant growth, making it valuable for farming and landscaping
- Game Mechanics: Understand the in-game process of combining these items and their effects on different plants
- Player Tips: Maximize your farming efficiency with this potent concoction; share your best practices

Crafting Recipe: Bone meal and spore blossoms combine to create a powerful fertilizer in Minecraft
In the world of Minecraft, crafting recipes are essential for players looking to enhance their gameplay experience. One such recipe involves combining bone meal and spore blossoms to create a powerful fertilizer. This unique crafting combination can significantly boost crop growth rates, making it a valuable asset for any player focused on farming or sustainability within the game.
To craft this powerful fertilizer, players will need to gather both bone meal and spore blossoms. Bone meal can be obtained by grinding bones in a crafting table, while spore blossoms are typically found in the Nether dimension, often growing on the ground or on blocks. Once these ingredients are collected, players can combine them in a crafting table to create the fertilizer.
The process of combining bone meal and spore blossoms is straightforward. Players should place one bone meal and one spore blossom in a crafting table, and the resulting product will be a powerful fertilizer. This fertilizer can then be used on crops to accelerate their growth, making it an invaluable tool for players looking to maximize their agricultural output.
One of the key benefits of this crafting recipe is its efficiency. Unlike other fertilizers in the game, the combination of bone meal and spore blossoms provides a significant boost to crop growth rates without requiring additional resources or complex crafting processes. This makes it an accessible and practical option for players of all skill levels.
In conclusion, the crafting recipe that combines bone meal and spore blossoms to create a powerful fertilizer in Minecraft is a game-changer for players focused on farming and sustainability. By following the simple steps outlined above, players can unlock the potential of this unique combination and enjoy the benefits of accelerated crop growth.
Unveiling the Lifespan of Ringworm Spores: A Comprehensive Guide
You may want to see also
Explore related products

Ingredient Sources: Bone meal is obtained from bones, while spore blossoms are found in the Nether
Bone meal, a key ingredient in many agricultural and horticultural practices, is derived from animal bones that have been processed and ground into a fine powder. This substance is rich in nutrients such as phosphorus, calcium, and nitrogen, making it an excellent fertilizer for promoting healthy plant growth. In contrast, spore blossoms are a rare and exotic plant species found exclusively in the Nether, a dimension characterized by its harsh, infernal environment. These blossoms are known for their unique properties and are often sought after by adventurers and botanists alike.
The process of obtaining bone meal involves collecting animal bones, which can be sourced from various places such as slaughterhouses, farms, or even household waste. Once collected, the bones are cleaned, dried, and then ground into a fine powder using specialized machinery. This powder can then be applied directly to soil or mixed with other fertilizers to enhance its effectiveness. On the other hand, acquiring spore blossoms requires a more specialized approach, as they can only be found in the Nether. Adventurers must navigate the treacherous terrain of this dimension, avoiding dangers such as lava lakes, fire, and hostile mobs, in order to locate and harvest these elusive plants.
When it comes to using bone meal on spore blossoms, it is important to consider the specific needs of these plants. While bone meal can provide essential nutrients, it is also crucial to ensure that the soil pH and moisture levels are appropriate for optimal growth. Additionally, spore blossoms may require specific light conditions and protection from pests and diseases, which must be taken into account when planning their cultivation. By understanding the unique properties of both bone meal and spore blossoms, gardeners and adventurers can work together to create a thriving environment for these extraordinary plants.
Unveiling the Microscopic World: The Size of Mold Spores Explained
You may want to see also
Explore related products

Usage Benefits: The mixture accelerates plant growth, making it valuable for farming and landscaping
The application of bonemeal to spore blossoms can significantly enhance plant growth, offering substantial benefits for both farming and landscaping. This organic fertilizer, rich in phosphorus and nitrogen, plays a crucial role in promoting healthy root development and improving soil structure. When used correctly, bonemeal can lead to more robust and resilient plants, capable of withstanding environmental stressors and diseases.
One of the key advantages of using bonemeal is its slow-release formula, which ensures a steady supply of nutrients to the plants over an extended period. This characteristic makes it particularly valuable for perennial plants and those with long growing seasons, as it reduces the need for frequent fertilization. Additionally, bonemeal's natural origin makes it an environmentally friendly choice, aligning with sustainable agricultural practices and organic gardening principles.
In the context of spore blossoms, bonemeal can be especially beneficial due to its ability to support the rapid growth and development of these unique plants. Spore blossoms, which are often used in landscaping for their striking appearance and low maintenance requirements, can thrive when provided with the right nutrients. By incorporating bonemeal into the soil, gardeners can create an optimal growing environment that encourages the proliferation of spore blossoms and enhances their visual appeal.
Furthermore, the use of bonemeal can contribute to improved soil health, which is essential for the long-term success of any gardening or farming endeavor. The nutrients in bonemeal help to balance the soil's pH levels and promote the growth of beneficial microorganisms, leading to a more fertile and productive growing medium. This, in turn, can result in higher crop yields and more vibrant, healthy plants.
In conclusion, the mixture of bonemeal and spore blossoms offers a range of usage benefits that can be highly valuable for both farming and landscaping. By accelerating plant growth, improving soil health, and providing a slow-release source of essential nutrients, bonemeal can help gardeners and farmers achieve their goals while promoting sustainable and environmentally responsible practices.
Exploring the Key Differences Between Seeds and Spores
You may want to see also
Explore related products

Game Mechanics: Understand the in-game process of combining these items and their effects on different plants
In the game, combining bonemeal with spore blossoms can have various effects on different plants, depending on their specific needs and growth stages. Bonemeal is a fertilizer that provides essential nutrients to plants, promoting healthy growth and development. Spore blossoms, on the other hand, are a type of plant that can be used to create spore prints, which are then used to grow new plants.
When combining bonemeal with spore blossoms, it's important to understand the specific needs of the plants you're working with. For example, some plants may require more nutrients than others, and using too much bonemeal can actually harm them. Additionally, the timing of when you apply the bonemeal can also affect the outcome. Applying it too early or too late in the growth cycle can reduce its effectiveness or even cause negative effects.
To successfully combine bonemeal with spore blossoms, you'll need to experiment and find the right balance for each plant. Start by researching the specific needs of the plants you're working with, and then gradually introduce bonemeal into their growth cycle. Monitor the plants closely and adjust the amount and timing of the bonemeal as needed.
One common mistake players make when combining bonemeal with spore blossoms is using too much bonemeal. This can lead to nutrient burn, which can damage or even kill the plants. To avoid this, start with a small amount of bonemeal and gradually increase it as needed. Additionally, be sure to water the plants regularly to help flush out any excess nutrients.
In conclusion, combining bonemeal with spore blossoms can be a powerful tool for promoting healthy plant growth in the game. However, it's important to understand the specific needs of the plants you're working with and to use the bonemeal carefully to avoid negative effects. With practice and experimentation, you can master the art of combining bonemeal with spore blossoms and create thriving, healthy plants in your game.
Effective Ways to Eliminate Airborne Mold Spores
You may want to see also
Explore related products

Player Tips: Maximize your farming efficiency with this potent concoction; share your best practices
To maximize your farming efficiency, consider using a potent concoction of bone meal and spore blossoms. This combination can significantly boost crop yields and improve soil health. Bone meal is rich in phosphorus and nitrogen, essential nutrients for plant growth, while spore blossoms contain beneficial fungi that enhance nutrient absorption and protect against diseases.
When applying this mixture, it's crucial to follow the correct dosage and application method. Start by mixing one part bone meal with two parts spore blossoms. Then, evenly distribute the mixture around the base of your plants, ensuring it doesn't come into direct contact with the foliage to avoid burning. Water thoroughly after application to help the nutrients penetrate the soil.
Timing is also key. Apply the concoction during the early stages of plant growth, when the roots are developing, and again during the flowering stage for optimal results. Be cautious not to overapply, as excessive phosphorus can lead to environmental issues and negatively impact soil health.
In addition to using this potent mixture, there are other best practices to maximize your farming efficiency. Crop rotation, for instance, can help maintain soil fertility and reduce the risk of pests and diseases. Companion planting can also be beneficial, as certain plants can help deter pests and improve soil health.
By following these tips and using the bone meal and spore blossom concoction responsibly, you can significantly improve your farming efficiency and enjoy a bountiful harvest.
Ubiquitous Mold Spores: Understanding Their Presence in Our Environment
You may want to see also
Frequently asked questions
Yes, you can use bonemeal on spore blossoms in Minecraft. Bonemeal is a fertilizer that can be used to grow various plants, including spore blossoms, which are a type of flower that can be found in the Nether dimension.
When you use bonemeal on spore blossoms, it will cause them to grow and spread more quickly. This can be useful if you want to create a large number of spore blossoms in a short amount of time, or if you want to help them grow in a specific area.
In addition to helping spore blossoms grow, bonemeal can also be used to grow other types of plants, such as grass, flowers, and crops. It can also be used to speed up the growth of trees and other woody plants. Bonemeal is a versatile item that can be very helpful for players who want to create a lush and thriving environment in their Minecraft world.























![𝐁𝐄𝐒𝐓𝐒𝐄𝐋𝐋𝐄𝐑 Organic Bone Meal Fertilizer by Gardenera (4-12-0 NPK) All-Natural Plant Food Source of Nitrogen and Phosphorus for Bulbs, Gardens, Potted Plants, Trees, and Shrubs [8 OZ]](https://m.media-amazon.com/images/I/71+w8DPaTTL._AC_UL320_.jpg)